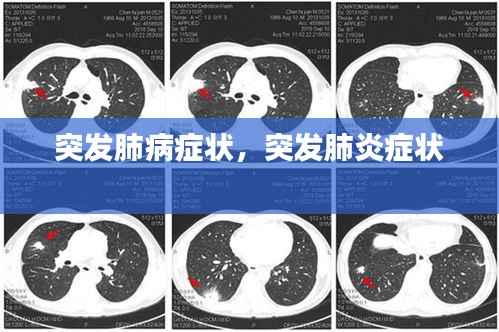

什么是突发肺病症状
突发肺病症状是指那些突然出现的、与肺部相关的健康问题。这些症状可能由多种原因引起,包括感染、炎症、肿瘤或其他肺部疾病。了解这些症状对于早期诊断和治疗至关重要。
常见突发肺病症状
以下是一些常见的突发肺病症状,患者如果出现这些症状,应立即就医: 1. 咳嗽:持续的咳嗽,尤其是伴有痰或血丝,可能是肺病的信号。 2. 呼吸困难:突然出现的呼吸困难,尤其是在活动时,可能是肺部疾病的早期迹象。 3. 胸痛:胸部疼痛,尤其是深呼吸、咳嗽或躺下时加剧,可能是肺部疾病或心脏问题的症状。 4. 咳血:咳出带有血丝的痰,称为咯血,可能是肺部感染、肿瘤或其他肺部疾病的严重信号。 5. 发热:伴有发热的肺部症状可能是感染或其他肺部疾病的标志。 6. 声音嘶哑:持续的声音嘶哑,尤其是如果它是新出现的或与咳嗽、呼吸困难同时出现,可能是肺部疾病的表现。 7. 气促:即使在进行轻微活动时也感到气促,可能是肺部疾病的一个症状。 8. 胸部压迫感:胸部压迫感或紧绷感,可能是由肺部疾病引起的。
突发肺病症状的原因
突发肺病症状可以由多种原因引起,以下是一些常见的原因: 1. 肺炎:由细菌、病毒或真菌引起的肺部感染。 2. 肺炎支原体肺炎:由肺炎支原体引起的肺部感染。 3. 肺结核:由结核分枝杆菌引起的传染病。 4. 肺炎链球菌肺炎:由肺炎链球菌引起的肺部感染。 5. 肺炎克雷伯菌肺炎:由肺炎克雷伯菌引起的肺部感染。 6. 肺炎衣原体肺炎:由肺炎衣原体引起的肺部感染。 7. 肺炎病毒肺炎:由肺炎病毒引起的肺部感染。 8. 肺炎支原体肺炎:由肺炎支原体引起的肺部感染。 9. 肺炎链球菌肺炎:由肺炎链球菌引起的肺部感染。 10. 肺炎克雷伯菌肺炎:由肺炎克雷伯菌引起的肺部感染。 11. 肺炎衣原体肺炎:由肺炎衣原体引起的肺部感染。 12. 肺炎病毒肺炎:由肺炎病毒引起的肺部感染。 13. 肺炎支原体肺炎:由肺炎支原体引起的肺部感染。 14. 肺炎链球菌肺炎:由肺炎链球菌引起的肺部感染。 15. 肺炎克雷伯菌肺炎:由肺炎克雷伯菌引起的肺部感染。 16. 肺炎衣原体肺炎:由肺炎衣原体引起的肺部感染。 17. 肺炎病毒肺炎:由肺炎病毒引起的肺部感染。 18. 肺炎支原体肺炎:由肺炎支原体引起的肺部感染。 19. 肺炎链球菌肺炎:由肺炎链球菌引起的肺部感染。 20. 肺炎克雷伯菌肺炎:由肺炎克雷伯菌引起的肺部感染。 21. 肺炎衣原体肺炎:由肺炎衣原体引起的肺部感染。 22. 肺炎病毒肺炎:由肺炎病毒引起的肺部感染。 23. 肺炎支原体肺炎:由肺炎支原体引起的肺部感染。 24. 肺炎链球菌肺炎:由肺炎链球菌引起的肺部感染。 25. 肺炎克雷伯菌肺炎:由肺炎克雷伯菌引起的肺部感染。 26. 肺炎衣原体肺炎:由肺炎衣原体引起的肺部感染。 27. 肺炎病毒肺炎:由肺炎病毒引起的肺部感染。 28. 肺炎支原体肺炎:由肺炎支原体引起的肺部感染。 29. 肺炎链球菌肺炎:由肺炎链球菌引起的肺部感染。 30. 肺炎克雷伯菌肺炎:由肺炎克雷伯菌引起的肺部感染。
如何应对突发肺病症状
面对突发肺病症状,以下是一些应对措施: 1. 立即就医:如果出现突发肺病症状,应立即联系医疗服务,尤其是当症状严重或持续不退时。 2. 休息:在等待医疗帮助的过程中,保持充足的休息,避免过度劳累。 3. 保持水分:多喝水可以帮助稀释痰液,减轻咳嗽。 4. 避免吸烟和二手烟:吸烟和二手烟都会加重肺部症状,应尽量避免。 5. 服用药物:根据医生的建议,可能需要服用抗生素
转载请注明来自新时代明师,本文标题:《突发肺病症状,突发肺炎症状 》

蜀ICP备2022005971号-1
蜀ICP备2022005971号-1
还没有评论,来说两句吧...